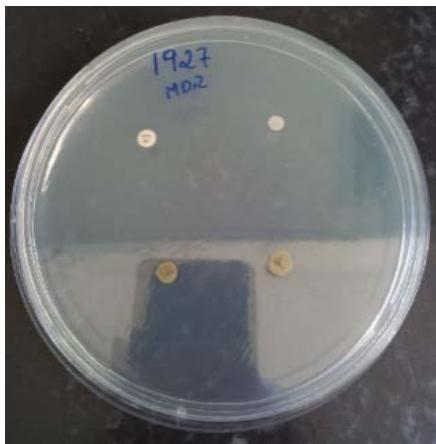
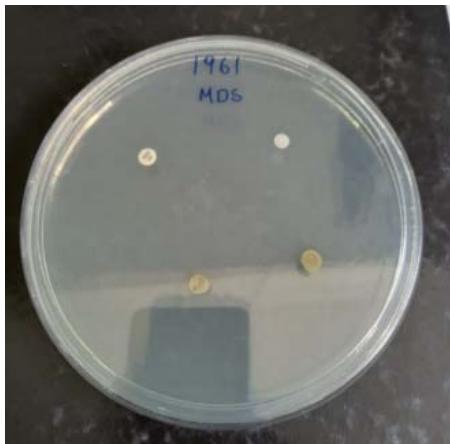
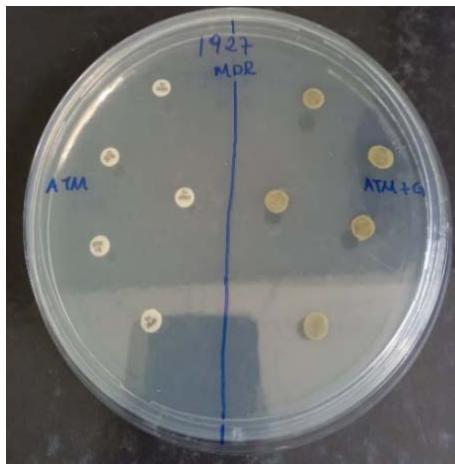
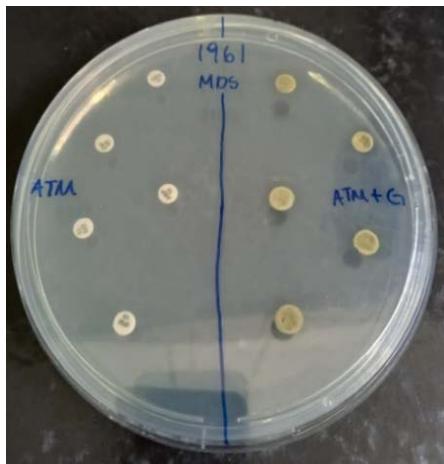
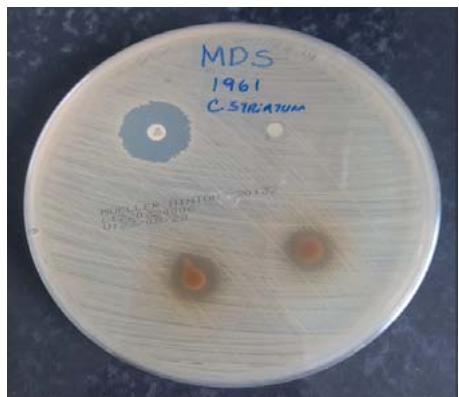
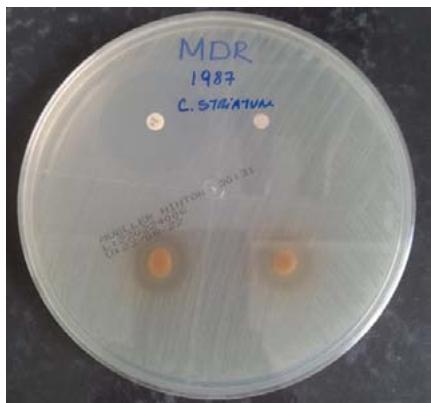
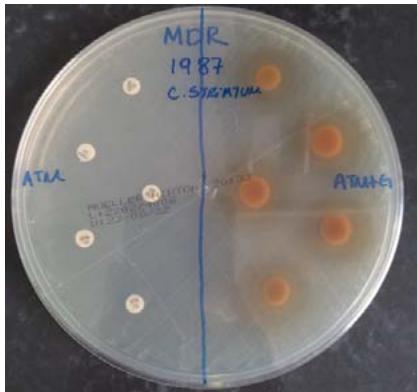
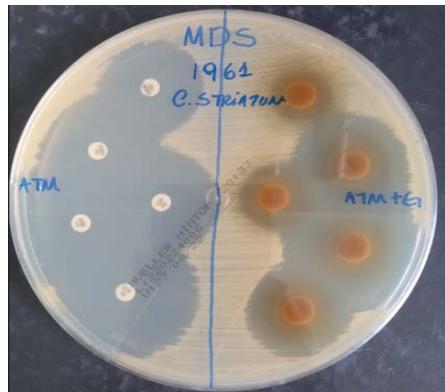

Detection of the Inhibitory Potential of Psidium Guajava L. Extract in Multidrug-Resistant Corynebacterium Striatum Strains Isolated from Nosocomial Outbreaks
Corynebacterium striatum is an emerging Gram-positive bacillus that presents tropism for thehuman microbiota, however, it has a high probabilityofpresenting a multidrug-resistant (MDR) profile. In addition, severalstudiesindicate its abilityto cause seriousinfections in patients with varying levels of immune compromise. C. striatum samples may present different virulence mechanisms such as; disinfectant tolerance, motility, and bacterial biofilm formation. This work aims to evaluate the antimicrobial activity of the hydroalcoholic extract of Psidium guajava L. on MDR and MDS strains of C. striatum an alternative for treatment. We used the agar disk diffusion method to evaluate the susceptibility of bacterial samples under conditions of treatment with Psidium guajava L.
## I. INTRODUCTION
The genus Corynebacterium belongs to Actinobacteria class represents a diverse group of Gram-positive bacteria. (Ramoset al., 2014) Bacteria of the genus Corynebacterium are grampositive rods of aerobic or facultative anaerobic growth, immobile, incapable of forming spores, and catalase positive. The description of the appearance of Corynebacterium in direct bacterioscopy using the Gram method often appears as irregular gram-positive rods (PIBG) arranged in the form of palisades, which may have different arrangements and lengths (Potonet et al., 2020). Currently, the genus Corynebacterium consists of 115 validly described species (Euzébyet al., 2014), and a little more than 50 species appear occasionally or rarely, causing infections in humans (Bernardet et al., 2012).
Corynebacteria are distributed in a wide range of ecological environments, such as soil, sewage and plant surfaces, some of which are pathogens for animals and humans. The best-known species of the genus is the human pathogen Corynebacterium diphtheriae, the etiologic agent of diphtheria (Jandaet al., 1998; Schroderet al., 2012).
Corynebacterium spp. belong to the skin and mucosal microbiota and are widely disseminated in the environment. There have been increasing reports of cases of human infections caused by some species of Corynebacterium, both in industrialized and developing countries, which can lead to death in immunocompromised and immunocompetent patients (Ramoset al., 2014).
Serious infections by Corynebacterium spp. expressing a multidrug resistance (MDR) profile to antimicrobial agents is attributed to samples of Corynebacterium jeikeium, cases of infections by MDR samples of other species have been described, including Corynebacterium urealyticum, Corynebacterium amycolatum, Corynebacterium afermentans, Corynebacterium pseudodiphtheriticum and Corynebacterium striatum, especially in healthcare settings (Wanget al., 2019).
Corynebacterium striatum, a species initially considered to be part of the normal amphibiotic microbiota of human skin and nasal mucosa, has been recognized as a potentially virulent pathogen capable of causing invasive infections and nosocomial outbreaks (Wonget al., 2010; Souzaet al., 2020). In recent decades, an increasing number of invasive infections caused by multidrug-resistant(MDR) and multi-sensitive (MDS) samples of C. striatum have been observed in immunocompromised and immunocompetent patients, including: pneumonia (Tarret al., 2003; Renomet al., 2007), sepsis (Dallet et al., 1989), synovitis and septic arthritis (Scholle et al., 2007), osteomyelitis (Fernandez-Ayalaet al., 2001), endocarditis, meningitis and recurrent bacteremia (Weiss et al., 1996; Syed et al., 2019). C. striatum has also been recognized as an etiologic agent of liver abscesses (Stone et al., 1997), peritonitis (Bhandari et al., 1995), surgical wounds (Moore et al., 2010), keratitis (Heidemann et al., 1991) and intrauterine infections (Boltinet al., 2009). The first case of urinary infection in an immunocompetent outpatient was observed in Spain (Beteta et al., 2009).
The number of case reports of C. striatum infection has increased in several developed countries, such as Italy, Spain, Netherlands, United States, Hong Kong and Japan (Campanile et al., 2009; Martins et al., 2009; Wong et al., 2010; Wang et al., 2019). Additionally, C. striatum has been isolated from different infections and nosocomial outbreaks in developing countries, including Brazil (Superti et al., 2009; Souza et al., 2019; Souza et al., 2020).
Epidemic outbreaks caused by MDR strains of C. striatum have been documented in patients hospitalized for long periods and, or continuously exposed to broad-spectrum antimicrobials in intensive care units (Boltin et al., 2009; Wong et al., 2010; Wang et al., 2019; Qiu et al., 2019). Using invasive medical devices and exposure to antimicrobial agents may favor respiratory tract mucosal infection the selection of MDR strains of C. striatum (Syed et al., 2019). Therefore, Gram-positive rod samples isolated from clinical material should not be simply discarded as mere contaminants, especially when obtained in pure culture from immunocompromised patients and using invasive devices (Martins et al., 2009; Wong et al., 2010; Baio et al., 2013; Souza et al., 2015).
Patients undergoing invasive medical procedures are susceptible to infections by C. striatum, because bacterial interaction with the surface of the abiotic substrate can allow colonization through the production of bacterial biofilm (Syed et al., 2019). Previous studies have also demonstrated the ability to spread C. striatum from patient to patient and through the contaminated hands of healthcare professionals (Brandenburg et al., 1996).
In a study published by Baio et al., (2013), phenotypic and genotypic characteristics of multidrug-resistant (MDR) and susceptible strains $(n = 14)$ of C. striatum isolated during an outbreak in 2009 at Hospital University Pedro Ernesto (HUPE) were described. Rio de Janeiro, Brazil. Subsequently, other strains were identified in HUPE itself and at the Hospital Municipal Jesus, revealing other multidrug-resistant pulses (Ramos et al., 2019; Souza et al., 2019; Souza et al., 2020).
The pathogen was isolated in the various sectors of the hospitals, from different anatomical sites, in adult individuals, where half the patients were 50 years of age or older. Most strains of C. striatum strains were isolated from tracheal aspirates, from patients undergoing endotracheal intubation procedures, and from blood in ICUs and surgical wards (Silva & Motta et al. 2022).
They were initially indicated by pulsed-field gel electrophoresis (PFGE-Pulsed-Field-Field Gel Electrophoresis), the presence of ten distinct clonal profiles (PFGE I, II, III and IV) with a predominance of pulse type I among, the samples. Clones I and II were isolated from tracheal secretion and blood. Type III and IV clones were isolated from urine and wound secretion, respectively. The authors identified the PFGE I, and II profiles as related clones of MDR strains. The PFGE III and IV profiles of C. striatum were identified as clones sensitive to the various drugs tested.
In bacteria, there is a mechanism that detects the density of other bacteria, called quorum sensing (Q.S.), which is a density sensor that is linked to a variety of physiological behaviors in bacteria (both Gram-negative and Gram-positive) (Zhao et al., 2020), which allows groups of bacteria to change behavior in synchronous ways in response to regulations of virulence factors, disinfectant tolerance, spore formation, toxin production, motility and bacterial biofilm formation (Mukherjee et al., 2019; Ding et al., 2020). In this system, bacteria control the behavior of the entire bacterial population to synthesize and secrete signaling molecules (called autoinducers), being able to communicate and orchestrate the structure and function of biofilms (Yu et al., 2020; Gopalakrishnan et al., 2021). But the change in the expression and behavior of its genes only happens when the signaling (self-inducing) reaches a limited concentration, being able to have communication, and synchronization in particular behaviors on a population scale, thus gaining the ability to function as a multicellular organism (Gopalakrishnan et al., 2020).
The biofilm can be defined as a set of bacteria firmly attached to a surface, encompassed by an extracellular matrix composed of polysaccharides, proteins and nucleic acids produced by the bacteria themselves (Costerton et al., 2003). The biological cycle for the formation of a biofilm goes through 5 stages, the first being contact, where it is reversible and is maintained by non-specific physicochemical interactions; The second stage being adhesion, where there is a change from the reversible to the irreversible step; The third being the formation of small settlement, with the bacteria secreting the signaling molecules and causing all the bacteria there to create a colony that works in sync and with this colony the mature biofilm is formed; The fourth stage being maturation, where the total formation of the biofilm is completed, being surrounded by various substances and creating a system of exchanges of nutrients that need to come out of the biofilm; And the fifth stage is the dispersion that occurs when the environment is not more favorable and consists of the detachment in the form of cell aggregates, to colonize new habitats and restart the formation of recent biofilms (Monroe et al.,2007). During the stages of contact, adhesion and construction of small colonies, each bacterium starts to produce signaling molecules that, depending on the local stimuli and mainly on the concentration reached in the microenvironment, trigger the activation of specific genes with the change from the phenotype of planktonic bacteria to the biofilm phenotype, as illustrated in Figure 1 (Monroe et al., 2007). The extracellular envelope protects them against physical and chemical aggressions from the external environment, such as the action of ultraviolet rays and changes in pH and osmolarity, in addition to significantly reducing the activity of adaptive and innate mechanisms of the immune system, such as the action of phagocytic cells and opsonization of antibodies (Hoyle & Costerton 1991).
The increase in bacterial resistance to the various antimicrobial agents used in the clinic is a global Public Health problem that draws the attention of national and international government agencies such as the World Health Organization (WHO), the Centers for Disease Control and Prevention (CDC/USA), ANVISA, as well as Committees on Hospital Infections (CCIH) from various health institutions (Oliveira et al., 2009).
Resistance to a particular antimicrobial may be an intrinsic property of a bacterial species or an acquired ability. Todevelop resistance, the bacterium must change its DNA, genetic material, which occurs in two ways: 1. induction of mutation in native DNA;
2. introduction of foreign DNA - resistance genes - that can be transferred between different genera or species of bacteria (ANVISA, 2007).
Cell membrane permeability is essential for the antibiotic to have the desired effect, be it bactericidal or bacteriostatic (Goodman& Gilman's, 2008). Drugs can enter the bacterial cell membrane in three ways: simple diffusion through the phospholipid bilayer, by diffusion facilitated by membrane proteins, called porins, or by self-promoted uptake, where the penetration of the drug into the bacteria is related to the characteristic physical chemistry of antibiotics, such as the polarity and sizes of molecules, modifying the liposaccharide content. Structures and amounts of porins, when they are modified, lead to bacterial resistance, as any decrease in the function and quantity of porins will lower the level of antibiotic inside the bacterial cell (Costa & Silva Junior, 2017).
Most antibiotics specifically bind to their targets with high affinity and thus prevent normal target activity. However, structural changes in the target that prevent effective binding between the target and the antibiotic confer resistance (Blair et al., 2015). Alternatively, a newly acquired gene may act to modify a target, making it less vulnerable to a particular antimicrobial. Thus, this gene carried by plasmid or transposon encodes an enzyme that inactivates targets or alters the binding of antimicrobials in order to prevent the occurrence of any inhibitory or bactericidal effect (ANVISA, 2007).
Efflux pumps are membrane proteins that export antibiotics to the extracellular environment, keeping intracellular concentrations at low levels. that code for different antibiotic transporters (Costa & Silva Junior, 2017).
The enzymatic mechanism of resistance occurs due to the inactivation of the drug from the production, by the bacteria, of enzymes that degrade or inactivate the antibiotic. Involving three types of enzymatic reactions, such as hydrolysis, transfer of a chemical group or redox process (Costa & Silva Junior 2016). The classic example of this resistance mechanism is the production of $\beta$ -lactamase that hydrolyzes the $\beta$ -lactam ring of penicillins (Kumar & Varela 2013).
Studies described that multiple drug resistance (MDR) can be defined when gram-negative and gram-positive bacteria are resistant to three or more classes of antimicrobials. Pan-resistant bacteria (PANDR) are defined as resistant to all antimicrobial agents (Magiorakos et al., 2012).
Several studies have shown an increase in the rate of antimicrobial resistance among Corynebacterium species. Resistance to $\beta$ -lactams, Clindamycin, Erythromycin, Ciprofloxacin and Gentamicin has been reported, sometimes leading to the use of Vancomycin as the drug of choice. To date, vancomycin, teicoplanin and linezolid are the most effective agents in vitro against Corynebacterium (Martins et al., 2009; Yoon et al., 2011; Reddy et al., 2012; Wang et al., 2019).
Antibiotic resistance develops as a natural consequence of the ability of the bacterial population to adapt. The indiscriminate use of antibiotics increases the selective pressure and also the opportunity for the bacteria to be exposed to them. That opportunity facilitates the acquisition of resistance mechanisms (Santos, 2004).
Given the increasing reports on different bacterial genera presenting resistance to several antimicrobial agents, mainly in the last decades, concomitantly, the search for new substances with antimicrobial potential also grows exponentially (Carneiro et al., 2014).
One of these alternatives is the extract of Psidium guajava L., commonly known as guava, from the Myrtaceae family, is a plant native to tropical America (Sanchez et al., 2005), has been historically used in folk medicine, traditional for the treatment of different respiratory disorders, diabetes, hypertension, as well as analgesic, antipyretic, anti-inflammatory, healing and antimicrobial functions (Matos 2002; Fu et al., 2016).
In previous studies, the biological actions of the crude extract of the leaves of $P_{\cdot}$ guajava L. were proven in the treatment of diarrhea, dysentery, lung diseases, and bronchitis, other properties were also attested, giving the species antispasmodic, antimicrobial, anti-inflammatory, anticonvulsant, analgesic, antidiabetic, antihyperlipidemic and antioxidant (Souza et al., 2015).
According to Desotiin 2011, the antimicrobial effect of guava essential oil was proven, by the microdilution plate method, against some Gram-positive and Gram-negative microorganisms and yeasts.
Its main constituents are tannins, flavonoids, essential oils, sesquiterpenoid alcohols, and triterpenoid acids. The parts used by the plant are the bark, shoots, leaves, and roots. (Gondim et al., 2006; Amaral et al., 2006)
The combination of plant-derived products and conventional antimicrobial drugs is a promising strategy, as it can increase the effectiveness of antimicrobial agents in treating infections caused by multidrug-resistant microorganisms (Fernandes et al., 2012).
Therefore, we want to investigate the antibacterial action of leaves of P. guajava on the samples of C. striatum, in this way, also to evaluate its potential for synergistically modulate the action of antibiotic available for treatments against gram-positive bacteria of clinical importance.
Given the reports on different bacterial genera presenting resistance to various antimicrobial agents, mainly in the last decades, there is a need for the search for new substances with antimicrobial also increase (Carneiro et al., 2014).
About all the problems that we narrate, there is a need to seek new therapeutic alternatives to combat multidrug-resistant bacteria, where it will be necessary to have qualified pharmaceutical professionals to understand the importance of diagnosis and the functionality of antibiotics, who, together with pharmacological knowledge, can seek new ways of controlling or eliminating multidrug-resistant bacterial infections.
## II. MATERIALS AND METHODS
Mature leaves of $P.$ guajava $L.$ were collected in the lake's region, in the city of Armação dos Búzios, in a home plantation in the Vila Caranga neighborhood, on February 20th. To avoid contamination in the material, the leaves were washed in running water and then immersed in diluted chlorine at a concentration of (1:20) for one minute, as a subsequent rinse to remove the excess. Then the leaves were left on paper towels and under protection against the sun, waiting for the leaves to dry.
To obtain the hydroalcoholic extract, 100 grams of dry material were immersed in $500\mathrm{ml}$ of $70\%$ ethanol. The solution was stored in closed glass vials and wrapped in aluminum foil to prevent light interference. This condition was maintained for 15 days and shaken three times a day. After this interval, the solution was filtered using a funnel with hydrophilized gauze. To avoid the interference of ethanol in the test, the extract was evaporated in a water bath at $45^{\circ}\mathrm{C}$ until a viscous liquid was obtained. The solution was kept in a light-free environment. (Andrade et al., 2019) beingreadyto perform the antimicrobial test, $1\mathrm{ml}$ of $100\%$ extract was distributed in 6 sterile test tubes (Figure 01).
Two strains of C. striatum from a nosocomial outbreak started in 2009 and isolated from patients admitted to Hospital University Pedro Ernesto
(HUPE/USERJ) located in the metropolitan region of the state of Rio de Janeiro, Brazil, were used (Table 01).
The microorganisms are stored in Skim Milk at $-70^{\circ}\mathrm{C}$, in the Bacteriota of the Laboratory of Diphtheria, and Corynebacterioses of Clinical Importance – LDCIC – Discipline of Microbiology and Immunology – FCM/URJ, partner laboratory of the Faculty of the Lagos Region. Strains were thawed, reactivated and confirmed after new identification by conventional biochemical techniques and confirmed by automated methods such sequencing of 16S and rpoB genes and mass spectrometry (MALDI-TOF). Additionally, the samples were characterized by pulsed-field electrophoresis (PFGE) genetic analysis and were classified into different pulse type (Baio et al., 2013). For this work, we selected a multi-resistant strain MDR/RJ 1987/PFGE I and another MDS/RJ 1961 PFGE III Pulse types previously characterized and identified after the outbreak.
The inoculums were prepared and standardized in sterile saline solution, comparing the turbidities with the tube $n^0$ 0.5 of the McFarland scale to obtain about $10^{6}$ CFU/ml (Mendonça et al., 2016).
In two Petri dishes containing Mueller Hinton Agar as the culture medium, the bacterial inoculum prepared with the sterile saline solution (0.5 turbidity on the McFarland scale) was drained with sterile swabs and distributed. Uniformly over the agar surface (Silveira et al., 2009). The first plate with the MDR/RJ 1987/PFGE I strain, respectively, and the MDS/RJ 1961 PFGE III strain on the second plate. In the esection for 30 seconds at a concentration of $100\%$ of the extract in tube 1 of Figure 2 (Stieven et al., 2009For the negative control, we used disks with saline solution and for positive control, we used vancomycin (30mcg)(Figure 2). Then, with the plates already striated and with the discs, the inverted plates were incubated at $37^{\circ}C$ for 24 hours, after which the of inhibition zones were measured, in millimeters. The result was determined by comparative descriptive statistics from the growth inhibition halos (mm) found, using a universal caliper to the halos formed (Figure 3).
To determine the modulating effect, two Mueller Hinton agar plates were used, with sterile swabs, the Mc Farland 0.5 scale inoculum was used up, and, the strains MDR/RJ 1987/ was evenly distributed on the first plate. PFGE I and on the second plate the strain MDS /RJ 1961 PFGE III, the leaves were identified with the places where the antibiotics were placed in the extracts for 30 seconds, each antibiotic in tubes 2 to 6, respectively (Figure 4), and only the antibiotics. The antibiotics Gentamicin (GEN 10), Ciprofloxacin (CIP 05), Erythromycin (ERI 15), Imipenem (IPM 10) and Ampicillin (AMP 10) were used. The result is determined by comparing the halos of pure antibiotics and antibiotics dipped in the P.guajava L extract. Then, with the plates already streaked and with the disks, the plates were incubated at $37^{\circ} \mathrm{C}$ for 24 hours, and after this period, the inhibition zones were in millimeters. (Figure 5).
## III. RÉSULTADOS E DISCUSSÖES
Due to the abusive use of traditional antibiotics and the increasing increase in microbial resistance, clinical microbiologists have shown great interest in the investigating of plant extracts with antimicrobial potential (Volpato 2005).
The results related to the Disk Diffusion test in agar in the presence of the extract with antimicrobial expectation are described in Table 2. The bacterial strains, regardless of their resistance profile, MDS 1987 and MDR 1961, showed sensitivity to the $100\%$ crude extract of $P_{\cdot}$ guajava, showing inhibition halos of $13\mathrm{mm}$, and $14\mathrm{mm}$, respectively (Figure 5). Interestingly, our results corroborate the statements of Biswas et al., (2013), who showed that Gram-positive bacteria were more susceptible to an extract of $P_{\cdot}$ guajava (Biswas et al., 2013).
Also, in the studies by Sanches et al., (2005), it was possible to verify that the ethanol-based extracts: water from leaves, stem bark and roots of $P$ guajava showed activity against Staphylococcus aureus, gram-positive microorganisms, as well as our samples studied from Corynebacterium.
For Lopes et al., (2006) the formation of inhibition halos under the microorganisms tested is due to a synergistic effect of all its constituents, phytochemical compounds: tannin, phenols, flavonoids and alkaloids (Lopes et al., 2006). A study carried out by Alves et al., (2006) showed that the extract is capable of also having antifungal properties against strains of Candida albicans, Candida tropicalis, and Candidakrusei (Alves et al., 2006).
The results referring to the agar diffusion tests with evaluation of the antibacterial potential of the hydroalcoholic extract of $P.$ guajava in synergistic action showed complex and interesting results (Table 3). When the extract was synergistically exposed together with the discs containing antibiotics on the MDR 1987 sample isolated from the respiratory tract, it favored the inhibitory potential of all the antibiotics tested, since, without the action of the extract, the antibiotic discs alone were not able to inhibit the multiplication of this MDR Strain (Table 4 and Figure 5). Interestingly, demonstrating the need for more studies that can clarify several doubts about the resistance mechanisms of these C. striatum samples, the hydroalcoholic extract of $P.$ guajava, when exposed together with antibiotics, reduced the inhibition halos of the MDS 1961/ MDS in all antibiotics, when compared to discs without the extract (Tables 3 and Figure 5).
In this evaluation, gentamicin and erythromycin were the antibiotics that were most inhibited during the synergism process, significantly reducing their effectiveness by $58\%$ and $32\%$, respectively.
Table 4 shows that MDS 1961 strains did not achieve synergism. All ATM+G halos (antibiotic plus extract) decreased. A possible explanation is the presence of a secondary metabolite of the plant that caused interference in the antibiotic action and, or the possibility of the hydroalcoholic extract having diluted the antibiotic, consequently decreasing its activity and the size of the halo.
We observed better results with the MDR 1987 strain, table 4, where the bacterium was shown to be resistant to all antibiotics. Stilladded to the hydroalcoholic section, halos were formed, it is possible that the extract presents a certain metabolite that inhibited the mechanism of resistance of C striatum MDR 1987.
Simões et al., (2018) observed that the antimicrobial action of Psidium guajava might be related to the inhibition of bacterial enzymes, direct action on the membrane of microorganisms, or competition for metal ions, whichessentialfor microbial metabolism. With this, it can make the synergisticinteractions capable of increasing or improving the potency of antibiotics against a multidrug-resistant microorganism.
For Pereira et al., (2014), A strategy enhances the action of plant extracts, as well as to reverse the resistance of such strains to antibiotics that are already on the market, is to associate these natural products with drugs for clinical use, seeking to interactions the synergistic. Through this strategy, it can be seen in Table 4 that the synergism of the $P$. guajava extract with the antibiotics managed to inhibit and create halos of relatively positive sizes in the MDR strains, $90\%$ of them above $20\mathrm{mm}$.
The results obtained in this research are important to show that the antimicrobial activity of the extract used against the microorganism C. striatum was relevant as the strains MDR 1987 since the strains tested are directly related to the occurrence of cases of nosocomial outbreaks.
## IV. CONCLUSION
We can conclude that C. striatum remains an emerging and dangerous pathogen, capable of causing serious infections and promoting nosocomial outbreaks. inhibit or favor the antibiotic action of different antimicrobial agents when used in bacterial samples independent of the antimicrobial susceptibility profile. Additionally, the P. guajava extract also established important results in the tests combined with therapies, indicating possible selective synergism between the ATBs and the botanical extract in the Multidrug-resistant Exposures, modifying the susceptibility profile of the MDR samples, which started to show sensitivity to the tested ATBS, boosting the possibility for further studies that confirm the potential for selective action in MDR Selection. Given the current scenario with safe antimicrobial alternatives, and with the increase in multi-resistant microorganisms, researchers must continue the search for new therapeutic compounds, emphasizing that the extract of $P_{\cdot}$ guajava has great projection for different treatments, including antimicrobial.
- diseases: an official publication of the Infectious Diseases Society of America.
1996.
92. Wong KY, Chan YC & Wong CY. Corynebacterium striatum as an emerging pathogen. The Journal of Hospital Infection.
2010.
93. Zhao X, Yu Z & Ding T. Quorum-Sensing Regulation of Antimicrobial Resistance in Bacteria. Microorganisms. 2020; 8(3): 425. https://doi.org/10.3390/microorganisms8030425
 Figure 1
Legends: steriletest tubes containing 1ml ofextract. Source: the authors.
Figure 2
Legends: Paper discs impregnated with $100\%$ extract and positive and negative controls on Muller Hinton agar.
Figure 3
Legends: Antibiotics and antibiotics dipped in extract. ATM (Antimicrobial) ATM + G (Antimicrobial plus extract) Source: the authors
Figure 4
Legends: Result of $100\%$ gross extract obtained
Source: the authors
Figure 5
Legends: Synergism with the extract and antibiotics
Table 1: Microbiological aspects of Corynebacterium striatum strains used in this study previously isolated from patients of a university hospital located in the metropolitan area of Rio de Janeiro, Brazil*
<table><tr><td rowspan="2">Strain/PFGE-type*</td><td rowspan="2">Clinical sites</td><td rowspan="2">Antimicrobials resistance profiles</td><td colspan="2">Biofilm on polyurethane catheter (CFU/ml)</td></tr><tr><td>37°C</td><td>20°C</td></tr><tr><td>1987/I</td><td>BAL</td><td>MDR</td><td>1.4x10^8</td><td>3.3x10^8</td></tr><tr><td>1961/III**</td><td>Urine</td><td>MDS</td><td>1.0x10^8</td><td>1.4x10^6</td></tr></table>
Table 2
<table><tr><td>SAMPLES</td><td>MDS 1961</td><td>MDR 1987</td></tr><tr><td>100% crude extract obtained</td><td>13 mm</td><td>14mm</td></tr><tr><td>Positive Control</td><td>25mm</td><td>40mm</td></tr><tr><td>Negative Control</td><td>-</td><td>-</td></tr><tr><td colspan="3">Legends: Disk diffusion halo results</td></tr></table>
Table 3
<table><tr><td>MDS 1961</td><td>ATM</td><td>ATM+G</td></tr><tr><td>Gentamicine</td><td>35mm</td><td>15mm</td></tr><tr><td>Ampicilline</td><td>41mm</td><td>36mm</td></tr><tr><td>Imipenem</td><td>53mm</td><td>46mm</td></tr><tr><td>Erythromycin</td><td>50mm</td><td>34mm</td></tr><tr><td>Ciprofloxacin</td><td>36mm</td><td>22mm</td></tr><tr><td colspan="3">Legends: Results of disk diffusion halos of synergism in MDS</td></tr></table>
Table 4
<table><tr><td>MDR 1987</td><td>ATM</td><td>ATM+ G</td></tr><tr><td>Gentamicine</td><td>-</td><td>19mm</td></tr><tr><td>Ampicilline</td><td>-</td><td>24mm</td></tr><tr><td>Imipenem</td><td>-</td><td>24mm</td></tr><tr><td>Erythromycin</td><td>-</td><td>23mm</td></tr><tr><td>Ciprofloxacin</td><td>-</td><td>23mm</td></tr><tr><td colspan="3">Legends: Results of disk diffusion halos of synergism in MDR</td></tr></table>
Generating HTML Viewer...
References
63 Cites in Article
E Adderson,J Boudreaux,R Hayden (2008). Infections caused by coryneform bacteria in pediatric oncology patients.
Alr Aguiar,H Dodou,Gwp Sales,M Rodrigues,Mam Bandeira,Nap Nogueira (2018). Atividade antimicrobiana do extrato de Psidiumguajava L. (goiabeira) e sinergismo com antimicrobianos convencionais.
Pollianna Alves,Pedro Leite,Jozinete Pereira,Luciana Pereira,Maria Pereira,Jane Higino,Edeltrudes Lima (2006). Atividade antifúngica do extrato de Psidium guajava Linn. (goiabeira) sobre leveduras do gênero Candida da cavidade oral: uma avaliação in vitro.
Fmm Amaral,Mns Ribeiro,Barbosa Filho,J Reis,A Nascimento,Frf Macedo,R (2006). Plants and chemical constituents with giardicidal activity.
Ana Andrade,Nayanne Magalhães,Alessandra Silva,Danielly Oliveira,Angélica Farias,Danielle Rios (2019). A ação antimicrobiana dos extratos alcoólicos e aquosos da folha da goiabeira (Psidium guajava L.) no controle de Staphylococcus aureus ATTCC 27922, Escherichia coli ATTCC 25922 e Listeria monocytogenes SCOTT A.
(2014). Controle de Infecção em Serviços da Saúde.
(2000). Curso Básico de Controle de Infecção Hospitalar.
C Arciola,Y An,D Campoccia,M Donati,L Montanaro (2005). Etiology of Implant Orthopedic Infections: A Survey on 1027 Clinical Isolates.
Cristiane Silva (2022). Proposta de avaliação de programas de controle de infecção hospitalar: validação das propriedades de medidas e diagnóstico parcial de conformidade em serviços de saúde do município de São Paulo.
Paulo Baio,Higor Mota,Andréa Freitas,Débora Gomes,Juliana Ramos,Lincoln Sant'anna,Mônica Souza,Thereza Camello,Raphael Hirata Junior,Verônica Vieira,Ana Mattos-Guaraldi (2013). Clonal multidrug-resistant Corynebacterium striatum within a nosocomial environment, Rio de Janeiro, Brazil.
A Bauer,W Kirby,Sheerris Jc&turck,M (1966). Antibiotic susceptibility testing by a standardized single disk method.
K Bernard,A Pancheco,I Cunningham,N Gill,T Burdz,D Wiebe (2013). Emendation of the description of the species Corynebacterium propinquum to include strains which produce urease.
L Beteta,L Prado,Mf& Olivares,Mtg Ruiz (2009). Cystitis and haematuria due to Corynebacterium Striatum. A case report and review.
S Bhalldari,J Meigh,L Sellars (1995). CAPD Peritonitis Due to <i>Corynebacterium Striatum</i>.
Bipul Biswas,Kimberly Rogers,Fredrick Mclaughlin,Dwayne Daniels,Anand Yadav (2013). Antimicrobial Activities of Leaf Extracts of Guava (<i>Psidium guajava</i>L.) on Two Gram-Negative and Gram-Positive Bacteria.
D Boltin,M Katzir,V Bugoslavsky,I Yalashvili,T Nissimov,M Fried,O Elkayam (2009). Corynebacterium striatum -a classic pathogen eluding diagnosis.
A Brandenburg,A Van Belkum,C Van Pelt,H Bruining,J Mouton,H Verbrugh (2020). Patient-to-patient spread of a single strain of Corynebacterium striatum causing infections in a surgical intensive care unit.
D Heidemann,S Dunn,T Aiken,J Diskin (1991). Corynebacterium striatum keratitis.
J Hoyle B & Costerton (1991). Unknown Title.
William Janda (1998). Corynebacterium species and the Coryneform bacteria Part I: new and emerging species in the genus Corynebacterium.
S Kumar,M Varela (2013). Molecular Mechanisms of bacterial Resistance to antimicrobial Agents.
R Leonard,D Nowowiejski,J Warren,D Finn,M Coyle (1994). Molecular evidence of person-to-person transmission of a pigmented strain of Corynebacterium striatum in intensive care units.
Dcdxp Lopes,Zmf Freitas,Santos Ep &tomassini Tcb (2006). Atividades antimicrobiana e fototóxica de extratos de frutos e raízes de Physalisangulata L.
A-P Magiorakos,A Srinivasan,R Carey,Y Carmeli,M Falagas,C Giske,S Harbarth,J Hindler,G Kahlmeter,B Olsson-Liljequist,D Paterson,L Rice,J Stelling,M Struelens,A Vatopoulos,J Weber,D Monnet (2012). Multidrug-resistant, extensively drug-resistant and pandrug-resistant bacteria: an international expert proposal for interim standard definitions for acquired resistance.
L Martinez-Martinez,M Ortega,A Suarez (1995). Comparison of E-test with broth microdilution and disk diffusion for susceptibility testing of coryneform bacteria.
Cas Martins,Lmd Faria,M Souza,T Camello,E Velasco,Hirata Júnior,R Thuler,L& Mattos-Guaraldi,A (2009). Microbiological and host features associated with corneybacteriosis in cancer patients: a five-years study.
Fja Matos (2002). Farmácias vivas: sistema de utilização de plantas medicinais projetados para pequenas comunidades.
Alexandre Mendonça,Amanda Carvalho,Maristela Ferreira,Maurício Resende Júnior (2016). A UTILIZAÇÃO DOS EXTRATOS HIDROALCOÓLICO E ALCOÓLICO DE Eugenia uniflora L. COMO AGENTE ANTIBACTERIANO.
D Monroe Looking for Chinks in the Armor of Bacterial Biofilms.
Keith Moore,Val Hall,Alan Paull,Trefor Morris,Sarah Brown,Dorothy Mcculloch,Mark Richardson,Keith Harding (2010). Surface bacteriology of venous leg ulcers and healing outcome.
Sampriti Mukherjee,Bonnie Bassler (2019). Bacterial quorum sensing in complex and dynamically changing environments.
E Nieto,F Soriano,A Vindel,J Saez-Nieto,P Valero-Guillén (2000). Biochemical, antimicrobial susceptibility and genotyping studies on Corynebacterium urealyticum isolates from diverse sources.
A Oliveira (2009). Healthcare-associated infection: challenges in its prevention and control.
Yoshihito Otsuka,Kiyofumi Ohkusu,Yoshiaki Kawamura,Shigeyoshi Baba,Takayuki Ezaki,Satoshi Kimura (2006). Emergence of multidrug-resistant Corynebacterium striatum as a nosocomial pathogen in long-term hospitalized patients with underlying diseases.
V Pereira,C Dias,M Vasconcelos,E Rosa,M Saavedra (2014). Antibacterial activity and synergistic effects between Eucalyptus globulus leaf residues (essential oils and extracts) and antibiotics against several isolates of respiratory tract infections (Pseudomonas aeruginosa).
A Poton (2022). Corynebacterium diphtheriae.
Xiaotong Qiu,Dongke Chen,Xuebing Wang,Haijian Zhou,Xuexin Hou,Jingshan Zhang,Mengtong Li,Zhenjun Li (2019). A novel isothermal amplification-based method for detection of Corynebacterium striatum.
Juliana Ramos,Izabel Rodrigues,Paulo Baio,João Veras,Rommel Ramos,Luis Pacheco,Vasco Azevedo,Raphael Hirata Júnior,Michel Marín,Ana Mattos-Guaraldi,Verônica Vieira (2018). Genome sequence of a multidrug-resistant Corynebacterium striatum isolated from bloodstream infection from a nosocomial outbreak in Rio de Janeiro, Brazil.
Juliana Ramos,Cassius Souza,Yuri Faria,Eliane Da Silva,João Veras,Paulo Baio,Sérgio Seabra,Lilian De Oliveira Moreira,Raphael Hirata Júnior,Ana Mattos-Guaraldi,Verônica Vieira (2019). Bloodstream and catheter-related infections due to different clones of multidrug-resistant and biofilm producer Corynebacterium striatum.
Cristiane Barata-Silva,Lisia Maria Gobbo Dos Santos,Santos Alves Vicentini-Neto,Carolina Duque Magalhães,Silvana Do Couto Jacob,Josino Costa Moreira (2014). Nanomedicamentos: regulamentação e controle de qualidade.
B Reddy,A Chaudhury,U Kalawat,R Jayaprada,Gsk Reddy,B Ramana (2012). Isolation, speciation, and antibiogram of clinically relevant non-diphtherial Corynebacteria (Diphtheroids).
F Renom,M Garau,M Rubi,F Ramis,A Galmes,J Soriano (2007). Nosocomial outbreak of Corynebacterium striatum infection in patients with chronic obstructive pulmonary disease.
Neviton Sanches,Diógenes Garcia Cortez,Michelle Schiavini,Celso Nakamura,Benedito Dias Filho (2005). An evaluation of antibacterial activities of Psidium guajava (L.).
G Santana,Cmf Silva,I Silva,Jgb Olivella,Lmo Fernandes,B Sued-Karam,C Santos,C Souza,A Mattos-Guaraldi (2021). Worldwide survey of Corynebacterium striatum increasingly associated with human invasive infections, nosocomial outbreak, and antimicrobial multidrug-resistance, 1976-2020.
Rebeca Santos,Erika Duran (2022). DIAGNÓSTICOS DE ENFERMAGEM MAIS FREQUENTES EM PACIENTES COM INFECÇÃO HOSPITALAR EM UM HOSPITAL UNIVERSITÁRIO.
David Scholle (2007). A Spontaneous Joint Infection with <i>Corynebacterium striatum</i>.
Lms Silveira,Rsg Olea,J Mesquita,Aln Cruz,J Mendes (2009). Metodologias de atividade antimicrobiana aplicadas a extratos de plantas: comparação entre duas técnicas de ágar difusão.
C Simões (2018). Farmacognosia: da planta ao medicamento.
Adenícia Souza,Milca Pereira,Márcia Rodrigues (1998). Descontaminação prévia de materiais médico-cirúrgicos: estudo da eficácia de desinfetantes químicos e água e sabão.
Cassius Souza,Yuri Faria,Lincoln Sant’anna,Vanilda Viana,Sérgio Seabra,Mônica Souza,Verônica Vieira,Raphael Hirata Júnior,Lílian Moreira,Ana Mattos-Guaraldi (2015). Biofilm production by multiresistant Corynebacterium striatumassociated with nosocomial outbreak.
C Souza (2014). Atividade de biocidas e produção de biofilme em Corynebacterium striatum.
Larissa Parada Leite,Giovanna Pessanha Cordeiro,Beatriz Costa Monteiro,Paulo Aguiar De Oliveira,Pedro Pimenta De Mello Spineti,Maria Campos Magalhães,Erika Gonçalves Campana,Andréa Araujo Brandão (2013). HIPERTENSÃO NA DOENÇA RENAL CRÔNICA EM TRATAMENTO CONSERVADOR.
T Souza Perfil cromatográfico do óleo essencial e diversidade quimiotípica de PsidiumguajavaL. Tese (Doutorado: Pós-Graduação em Produção Vegetal).
A Stieven,Jjs Moreira,C Silva (2009). Óleos essenciais de uvaia (Eugenia pyriformis Cambess): avaliação das atividades microbiana e antioxidante.
N Stone,P Gillett,S Burge (1997). Breast abscess due to <i>Corynebacterium striatum</i>.
Silvana Superti,Daniela Martins,Juliana Caierão,Fabiana Soares,Taísa Prochnow,Vlademir Cantarelli,Alexandre Zavascki (2009). Corynebacterium striatum infecting a malignant cutaneous lesion: the emergence of an opportunistic pathogen.
M Syed,N Ashcherkin,M Sundhu,L Hakam,S Gul (2019). Recurrent Bacteremia with Corynebacterium striatum After Prosthetic Valve Replacement: A Case Report.
P Tarr,F Stock,R Cooke,D Fedorko,D Lucey (2003). Multidrug‐resistant <i>Corynebacterium striatum</i> pneumonia in a heart transplant recipient.
A Medeiros,L Cheen,B Generoso,T Abrahão,G Silveira,W Mazer (2005). ESTUDO DA PENETRAÇÃO DE CLORETOS EM CONCRETOS EXPOSTOS POR DOIS ANOS EM AMBIENTE MARINHO.
C Wang,D Mattson,A Wald (2001). Corynebacterium jeikeium bacteremia in bone marrow transplant patients with Hickman catheters.
Xuebing Wang,Haijian Zhou,Dongke Chen,Pengcheng Du,Ruiting Lan,Xiaotong Qiu,Xuexin Hou,Zhiguo Liu,Lina Sun,Shuai Xu,Xingzhao Ji,Heqiao Li,Dan Li,Jingshan Zhang,Hui Zeng,Zhenjun Li (2019). Whole-Genome Sequencing Reveals a Prolonged and Persistent Intrahospital Transmission of Corynebacterium striatum, an Emerging Multidrug-Resistant Pathogen.
No ethics committee approval was required for this article type.
Data Availability
Not applicable for this article.
How to Cite This Article
Beatriz Rodrigues Ribeiro. 2026. \u201cDetection of the Inhibitory Potential of Psidium Guajava L. Extract in Multidrug-Resistant Corynebacterium Striatum Strains Isolated from Nosocomial Outbreaks\u201d. Global Journal of Medical Research - B: Pharma, Drug Discovery, Toxicology & Medicine GJMR-B Volume 23 (GJMR Volume 23 Issue B2).
Explore published articles in an immersive Augmented Reality environment. Our platform converts research papers into interactive 3D books, allowing readers to view and interact with content using AR and VR compatible devices.
Your published article is automatically converted into a realistic 3D book. Flip through pages and read research papers in a more engaging and interactive format.
Our website is actively being updated, and changes may occur frequently. Please clear your browser cache if needed. For feedback or error reporting, please email [email protected]
Thank you for connecting with us. We will respond to you shortly.
Lorem ipsum dolor sit amet, consectetur adipiscing elit. Ut elit tellus, luctus nec ullamcorper mattis, pulvinar dapibus leo.
Detection of the Inhibitory Potential of Psidium Guajava L. Extract in Multidrug-Resistant Corynebacterium Striatum Strains Isolated from Nosocomial Outbreaks